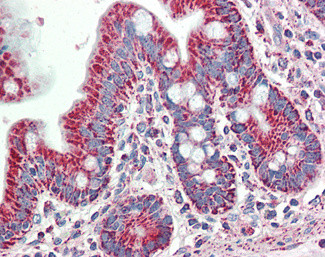
SLAMF8 Antibody in Immunohistochemistry (Paraffin) (IHC (P))

Search
Invitrogen
SLAMF8 Polyclonal Antibody
{{$productOrderCtrl.translations['antibody.pdp.commerceCard.promotion.promotions']}}
{{$productOrderCtrl.translations['antibody.pdp.commerceCard.promotion.viewpromo']}}
{{$productOrderCtrl.translations['antibody.pdp.commerceCard.promotion.promocode']}}: {{promo.promoCode}} {{promo.promoTitle}} {{promo.promoDescription}}. {{$productOrderCtrl.translations['antibody.pdp.commerceCard.promotion.learnmore']}}
产品信息
PA5-37955
种属反应
宿主/亚型
分类
类型
抗原
偶联物
形式
浓度
规格
纯化类型
保存液
内含物
保存条件
运输条件
RRID
产品详细信息
This antibody is predicted to react with mouse, rat and cow based on sequence homology.
This antibody is tested in Peptide ELISA: antibody detection limit dilution 8,000.
靶标信息
This gene encodes a member of the CD2 family of cell surface proteins involved in lymphocyte activation. These proteins are characterized by Ig domains. This protein is expressed in lymphoid tissues, and studies of a similar protein in mouse suggest that it may function during B cell lineage commitment. The gene is found in a region of chromosome 1 containing many CD2 genes.
仅用于科研。不用于诊断过程。未经明确授权不得转售。
篇参考文献 (0)
生物信息学
蛋白别名: B lymphocyte activator macrophage expressed; B-lymphocyte activator macrophage expressed; BCM-like membrane protein; CD353; FLJ20442; MGC129578; SLAM family member 8; unnamed protein product
基因别名: BLAME; CD353; SBBI42; SLAMF8
UniProt ID: (Human) Q9P0V8
Entrez Gene ID: (Human) 56833